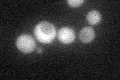
YGL091C
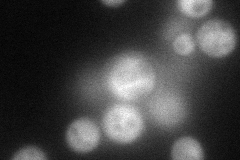
YGL091C
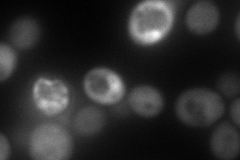
YGL091C
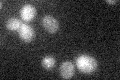
YGL091C

View description
Essential iron-sulfur cluster binding protein localized in the cytoplasm; forms a complex with Cfd1p that is involved in iron-sulfur protein assembly in the cytosol; similar to P-loop NTPases
Localization:
Intensity:
Fold change:
Significance:
-
C’ GFP library in SD
cytosol26.7 -
N' NOP1pr-GFP in SD
cytosol80.6594 -
N' TEF2pr-mCherry in SD
cytosol137.597 -
N' NATIVEpr-GFP in SD

cytosol36.0812 -
N' TEF2pr-VC and Cyto-VN in SD

cytosol46.1811 -
C’ GFP library in SD+DTT

cytosol30.221.13No -
C’ GFP library in SD+H2O2

cytosol30.111.12No -
C’ GFP library in Starvation Media
cytosol19.540.73No -
C’ GFP library on the background of Pup2-DaMP

N/A -
C’ GFP library on the background of CCT mutant

N/A0N/AYes
